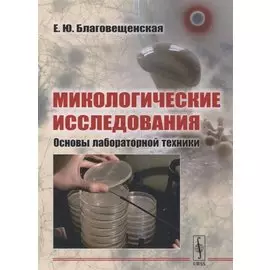
Микологические исследования: Основы лабораторной техники

Вы находитесь на странице "учебники по биологии ленанд". Здесь представлены товары российских и зарубежных компаний в количестве 35 шт., включая популярные мировые бренды. Доставка из интернет-магазинов возможна в такие города России как: Москва, Санкт-Петербург, Новосибирск, Екатеринбург, Казань, Нижний Новгород, Челябинск, Красноярск, Самара, Уфа, Ростов-на-Дону, Омск, Краснодар, Воронеж, Волгоград, Пермь и др. Каталог включает как доступные по цене товары, так и продукцию люксового сегмента.
-
 Ленанд969 ₽
Ленанд969 ₽Общая теория жизни. Диалектика формирования | Книга посвящена методологическим проблемам унификации биологического знания, логико-гносеологическим аспектам создания общей теории жизни. Прослеживаются ...
-
 Ленанд1096 ₽855 ₽-21%
Ленанд1096 ₽855 ₽-21%Философские основания классической биологии. Введение в органическую биологию | В книге обсуждаются особенности, истоки и развитие биологии как струю мышления. С начала Нового времени в науке о живом ...
-
 Ленанд1201 ₽
Ленанд1201 ₽Древо познания Биологические корни человеческого понимания | Категория: биология человека. антропология, биологические науки.
-
 Ленанд430 ₽
Ленанд430 ₽Проблема смерти и бессмертия Борьба организма со старостью | Категория: биология человека. антропология, биологические науки.
-
 Ленанд759 ₽
Ленанд759 ₽Занимательная микология | В настоящей книге в популярной форме описаны особенности строения, физиологии и образа жизни большой группы организмов - грибов, их биотические связи с растениями и животными...
-
 Ленанд423 ₽
Ленанд423 ₽Эволюционно-антропологические исследования в России и СССР XIX XX вв | Книга посвящена истории эволюционной антропологии в России. В ней также прослежено развитие мировой эволюционной мысли, начиная с...
-
 Ленанд605 ₽
Ленанд605 ₽Эволюция мозга человека Анализ эндокраниометрических признаков гоминид | Категория: биология человека. антропология, биологические науки.
-
 Ленанд794 ₽
Ленанд794 ₽Очерки методологии биологического исследования Система методов биологии | Категория: биология человека. антропология, биологические науки.
-
![Антропология с прагматической точки зрения]() Ленанд373 ₽317 ₽-15%
Ленанд373 ₽317 ₽-15%Антропология с прагматической точки зрения | Категория: биология человека. антропология, биологические науки.
-
![Биосфера и человек Экология взаимодействия]() Ленанд1024 ₽
Ленанд1024 ₽Биосфера и человек Экология взаимодействия | В книге рассмотрена общая картина эволюции Вселенной от Большого Взрыва до формирования современной цивилизации. Приводятся основные представления о биосфе...
-
![Развитие конечностей амфибий и их значение в вопросе о происхождении конечностей наземных позвоночных]() Ленанд748 ₽
Ленанд748 ₽Развитие конечностей амфибий и их значение в вопросе о происхождении конечностей наземных позвоночных | Категория: общая биология, биологические науки.
-
![Эволюционная теория И И Шмальгаузена От эволюции онтогенеза до биогеоценотической регуляции эволюции в кибернетической трактовке]() Ленанд627 ₽
Ленанд627 ₽Эволюционная теория И И Шмальгаузена От эволюции онтогенеза до биогеоценотической регуляции эволюции в кибернетической трактовке | Категория: общая биология, биологические науки.
-
![От амебы до робота Модели поведения]() Ленанд861 ₽
Ленанд861 ₽От амебы до робота Модели поведения | Есть ли общее в поведении животных и человека? Каковы основные процедуры, которые организуют то, что мы называем целесообразным поведением и разумным поведением? ...
-
![Биокомпьютер человека Состав структура свойства]() Ленанд402 ₽
Ленанд402 ₽Биокомпьютер человека Состав структура свойства | Категория: биология человека. антропология, биологические науки.
-
![Краткий очерк теории Дарвина]() Ленанд378 ₽
Ленанд378 ₽Краткий очерк теории Дарвина | Вниманию читателей предлагается книга, написанная выдающимся биологом, блестящим знатоком и защитником теории Дарвина — К. А. Тимирязевым, и ставшая в свое время лучшим ...
-
![Понятие жизни в натуралистской биологии]() Ленанд312 ₽
Ленанд312 ₽Понятие жизни в натуралистской биологии | Категория: общая биология, биологические науки.
-
![Иван Петрович Павлов Жизнь Научное творчество Современное состояние учения]() Ленанд1012 ₽
Ленанд1012 ₽Иван Петрович Павлов Жизнь Научное творчество Современное состояние учения | Книга одного из ведущих советских физиологов повествует о жизни и деятельности И. П. Павлова — величайшего ученого, внесшег...
-
![Основные факторы макроэволюции]() Ленанд564 ₽
Ленанд564 ₽Основные факторы макроэволюции | Категория: общая биология, биологические науки.
-
![Биофизика органов чувств]() Ленанд479 ₽
Ленанд479 ₽Биофизика органов чувств | В книге изложены биофизические основы и механизмы функционирования органов чувств не только человека, но и животных. В ней проводятся параллели между функционированием разны...
-
![Твои возможности человек]() Ленанд754 ₽
Ленанд754 ₽Твои возможности человек | Категория: биология человека. антропология, биологические науки.
-
![Происхождение человеческих рас Австралия и Океания]() Ленанд983 ₽
Ленанд983 ₽Происхождение человеческих рас Австралия и Океания | Категория: биология человека. антропология, биологические науки.
-
![Электричество в живых организмах]() Ленанд639 ₽
Ленанд639 ₽Электричество в живых организмах | Категория: общая биология, биологические науки.
-
![Сетевые структуры в биосистемах и человеческом обществе Децентрализованные распределенные структуры в природе как образцы для самоорганизации и построения эффективного и гуманного общества в информационную эпоху]() Ленанд943 ₽
Ленанд943 ₽Сетевые структуры в биосистемах и человеческом обществе Децентрализованные распределенные структуры в природе как образцы для самоорганизации и построения эффективного и гуманного общества в информаци...
-
![Новый курс в биологии К принципиальному обоснованию учения Ламарка]() Ленанд404 ₽
Ленанд404 ₽Новый курс в биологии К принципиальному обоснованию учения Ламарка | Категория: общая биология, биологические науки.
-
![Клеточная биоэнергетика Физико-химические и молекулярные основы]() Ленанд727 ₽
Ленанд727 ₽Клеточная биоэнергетика Физико-химические и молекулярные основы | В учебном пособии обобщены современные биофизические представления о механизмах преобразования энергии в живых системах. Детально расс...
-
![Биология клетки Физико-химические структурно-функциональные и информационные основы]() Ленанд1348 ₽
Ленанд1348 ₽Биология клетки Физико-химические структурно-функциональные и информационные основы | Категория: микробиология. вирусология, биологические науки.
-
![Микологические исследования: Основы лабораторной техники]() Ленанд506 ₽
Ленанд506 ₽Микологические исследования: Основы лабораторной техники | Данное пособие представляет обобщение накопленного материала в области экспериментальной микологии по различным особенностям работы с грибным...
-
![Краткий очерк теории Дарвина]() Ленанд378 ₽
Ленанд378 ₽Краткий очерк теории Дарвина | Вниманию читателей предлагается книга, написанная выдающимся биологом, блестящим знатоком и защитником теории Дарвина — К. А. Тимирязевым, и ставшая в свое время лучшим ...
-
![Сетевые структуры в биосистемах и человеческом обществе. Децентрализованные распределенные структуры в природе как образцы для самоорганизации и построения эффективного и гуманного общества в информационную эпоху]() Ленанд943 ₽
Ленанд943 ₽Сетевые структуры в биосистемах и человеческом обществе. Децентрализованные распределенные структуры в природе как образцы для самоорганизации и построения эффективного и гуманного общества в информац...
-
![Философские проблемы биологии и медицины. Выпуск 13. Феномен биорациональности]() Ленанд969 ₽
Ленанд969 ₽Философские проблемы биологии и медицины. Выпуск 13. Феномен биорациональности | В работе предлагается к обсуждению тип научной рациональности в так называемых «органических науках» — науках о феномен...
-
![Занимательная микология]() Ленанд759 ₽
Ленанд759 ₽Занимательная микология | В настоящей книге в популярной форме описаны особенности строения, физиологии и образа жизни большой группы организмов - грибов, их биотические связи с растениями и животными...
-
![Философские проблемы биологии и медицины. Выпуск №14. Вызовы техногенной цивилизации - интегративная философия мироподобия]() Ленанд869 ₽
Ленанд869 ₽Философские проблемы биологии и медицины. Выпуск №14. Вызовы техногенной цивилизации - интегративная философия мироподобия | В сборнике представлены тезисы докладов и сообщений участников четырнадцато...
-
![Клеточная биоэнергетика. Физико-химические и молекулярные основы]() Ленанд727 ₽
Ленанд727 ₽Клеточная биоэнергетика. Физико-химические и молекулярные основы | В учебном пособии обобщены современные биофизические представления о механизмах преобразования энергии в живых системах. Детально рас...
-
![Философские проблемы биологии и медицины. Выпуск 15: Парадигмы исследования и образования]() Ленанд869 ₽
Ленанд869 ₽Философские проблемы биологии и медицины. Выпуск 15: Парадигмы исследования и образования | В сборнике представлены тезисы докладов и сообщений участников пятнадцатой ежегодной конференции «Философски...
-
![Философские проблемы теоретической биологии]() Ленанд869 ₽
Ленанд869 ₽Философские проблемы теоретической биологии | Работа посвящена философским основаниям формирующейся теоретической биологии, общей теории жизни, или биотики. В плане диалектики общего, особенного и еди...